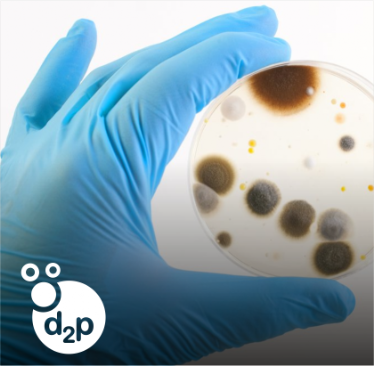

Symphony
Symphony

Polymer Solutions S.A. de C.V., es distribuidor autorizado en México de Symphony, que cuenta con una amplia gama de tecnologías para plásticos con vida contralada. Nuestro personal experto ofrece seguimiento y soporte técnico en temas relacionados con calidad, degradabilidad y vida de anaquel.
PRODUCTOS Y SOLUCIONES

Es un masterbatch a base de polímeros que controla y acelera el proceso de degradación y biodegradación, sin dejar residuos tóxicos o fragmentos de plástico.

Es un masterbatch antimicrobiano y fungicida que sirve como protección eficaz contra microorganismos.

Es un equipo capaz de detectar la presencia del aditivo d2w® y d2p® y en concentraciones adecuadas.
CONOCE MÁS